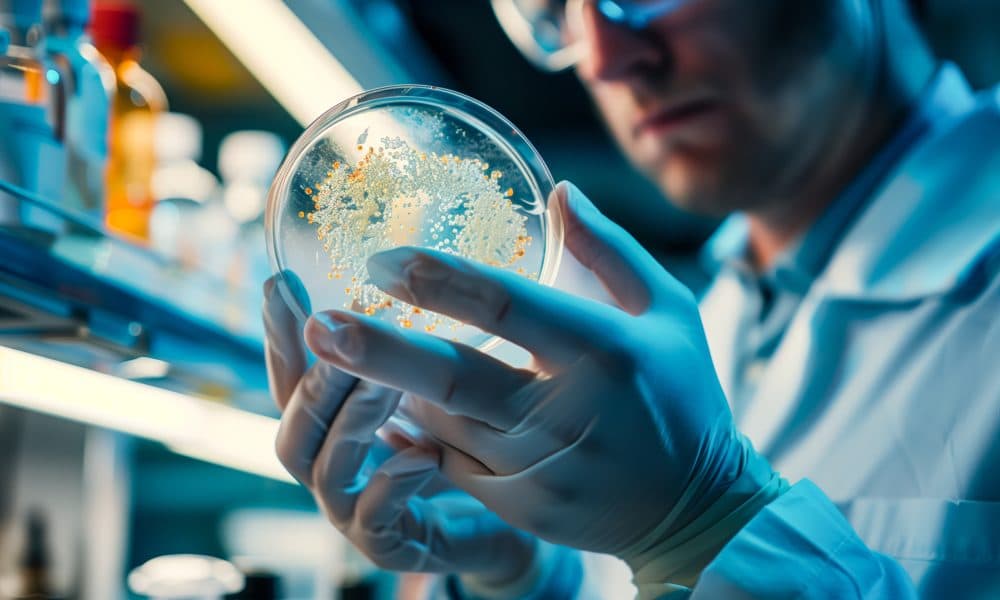
‘Parkinson’s in a dish’ model accelerates brain disease research

Researchers in the US have developed a model that rapidly converts stem cells to brain cells with protein structures characteristic of Parkinson’s disease (PD), enabling the study of the condition’s unique and highly variable disease pathology in a petri dish.
The study details how the model can one day be used to develop personalised diagnostic and treatment methods for Parkinson’s disease.
The study’s senior author is Vikram Khurana, MD, PhD, chief of the Movement Disorders Division at Brigham and Women’s Hospital (BWH) and principal investigator within the Ann Romney Center for Neurologic Diseases at BWH.
The researcher said: “We sought to assess how quickly we could make human brain cells in the lab that give us a window into key processes occurring in the brains of patients with Parkinson’s disease and related disorders like multiple system atrophy and Lewy body dementia.
“And, unlike previous models, we wanted to do this in a short enough timeframe for these models to be useful for high-throughput genetic and drug screens and easy enough for many labs to use across academia and industry.”
Parkinson’s, along with other neurodegenerative conditions like Alzheimer’s disease, causes protein build-up in neurons, leading to protein misfolding and impaired cell function.
Current therapies can alleviate some symptoms but do not address the root cause of the protein misfolding.
Existing “Parkinson’s in a dish” models can effectively transform stem cells into brain cells, but not within a reasonable timeframe to study patient-specific cellular pathologies to guide tailored treatment strategies.
This is important because patients with PD are diverse and a one-size-fits-all treatment strategy may now work for some patients.
The Brigham research team’s technology not only enables the transformation from stem cells to brain cells to occur reproducibly within weeks instead of months, but also allows researchers to develop models that reflect the diverse protein misfolding pathologies that can occur in the brain in that timeframe.
Khurana said: “The problem is that the way protein clusters form in PD looks different in different patients, and even in different brain cells of the same patient.
“This begs the question: how do we model this complexity in the dish? And how do we do it fast enough for it to be practical for diagnostics and drug discovery?”
To create this model, Khurana’s lab used special delivery molecules called PiggyBac vectors to introduce specific cellular instructions, known as transcription factors, to quickly turn stem cells into different types of brain cells.
They then introduced aggregation-prone proteins like alpha-synuclein, which is central to the formation of protein clusters in PD and related disorders, in nerve cells.
Using CRISPR/Cas9 and other screening systems, they identified diverse types of inclusions forming in the cells, some of them protective and some of them toxic.
To prove relevance to disease, they used their stem-cell models to discover similar inclusions in actual brains from deceased patients.
The work enables new approaches for classifying protein pathologies in patients and determining which of these pathologies might be the best drug targets.
While marking progress, the model has several limitations researchers aim to address.
For one, it currently generates immature neurons.
The researchers aim to replicate this model with mature neurons to model the effects of ageing on the protein aggregates that form.
While the new system can rapidly create both neurons and key inflammatory “glial” cells in the brain, the current paper only examines these cells individually.
The team is now combining these cells together to study the inflammatory responses to the protein aggregation process that might be important for PD progression.
The two lead authors on the study, both research fellows in the Department of Neurology at BWH, commented on the clinical applications that are already underway in the lab.
Co-first author, Alain Ndayisaba, MD, said: “In one key application, we are utilising this technology to identify candidate radiotracer molecules to help us visualise alpha-synuclein aggregation pathologies in the brains of living patients we see in the clinic.
First author, Isabel Lam, PhD, added: “This technology will pave the way for rapidly developing ‘personalised stem cell models’ from individual patients.
These models are already being used to efficiently test new diagnostic and treatment strategies ‘in a dish’ before jumping into clinical trials so we target the right drug to the right patient.










